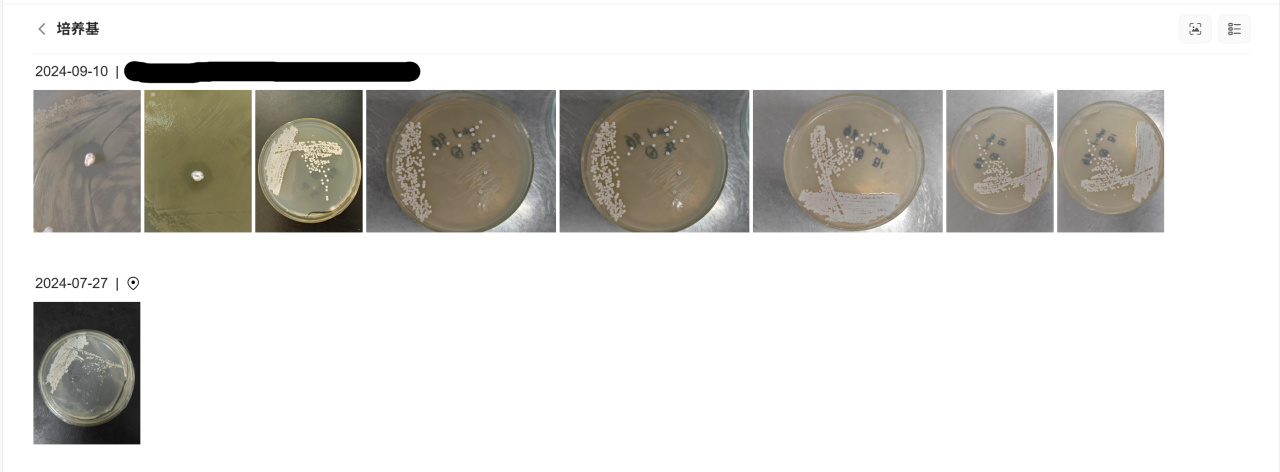

你是否需要一台NAS?
作为DXP2800用户,通过半年多的体验折腾,我对上述疑问有了新的看法。随着互联网分享精神的日渐衰落,攒点自己的私人珍藏成了本人十分迫切的需求。
同时实验送样反馈的基因组数据需要备份与分享,各类自媒体工作文件也不能落下,这些都是值得留存的数据。同时也想体验一下例如Docker和虚拟机等NAS进阶功能。
于是本人选择了可玩性更高,支持更多额外功能&拓展的绿联DXP2800,x86架构的N100处理器双盘位NAS,价格也能接受。

虽然DXP2800虽可玩性极高,但暂时失去国补价格接近1800元(空盘版)的它的确让不少用户望而却步。
作为一般用户,ARM架构的更易用型NAS反倒成为新的宠儿,能够满足基本的观影、备份与分享需求,能耗更低的同时价格也相对便宜。
这也是绿联在巩固DXP系列后不久,迅速推出绿联DH4300 Plus 用于打头阵的原因。
外观&配置
1299元,给到8GB LPDDR4X+ARM八核处理器,满足日常需求没问题,最重要的是比DXP4800DXP2800多两个盘位,来到支持最大120TB的四盘位的同时,甚至价格还能便宜500... ...
对折腾自组NAS没啥精力,整个成品NAS呗。
用来看看蓝光影片,备份多平台数据/照片,顺手分享一下文件给朋友等这类一般需求,绿联DH4300 Plus也许会是更合适的选择。
形态上,DH相较于DXP系列更为活泼一些,更适合家庭客厅场景。蓝灰色塑料壳体,漆面依旧不马虎,不弱于金属材质的DXP系列。
最大的区别还是在于硬盘放置固定形式不同,DXP系列为正面抽屉形式,带独立的锁孔,多盘位版本为长条形,更易放入机柜。而DH系列则为硬盘竖装,整体设计偏方形而非长条形,相对节约空间。
为了迎合新的硬盘笼设计,DH4300 Plus上盖也改为磁吸形式进行固定,取下即可更换硬盘。

散热风道为上下贯穿形式,取下所有硬盘笼可见其几乎占据整个NAS底部的大号风扇,与小巧的主板。整体设计相较于既带M.2槽位,又支持内存更换DXP系列,要更为简约。

正面则相对简约,可见绿联的Logo和产品名,倒是新增一个便于手机下载绿联云APP和登录的NFC触碰标志。背面则为出风口,覆盖整个面。

接口方面,正面为一个高速USB-C接口,3.2Gen1速率,以及硬盘指示灯与LAN(网络)状态指示灯。
背面则为一个HDMI(外接屏幕)、两个USB-A接口,和前置的C口速率规格一致、一个2.5G网口与Reset重置键。
相较于支持双网口,带读卡器的DXP系列NAS,DH4300 Plus的接口更偏于满足基本的网络与拓展需求,单网口和USB-A/C接口应付家庭内网和存储场景足矣。

DH4300 Plus硬盘需要通过螺丝固定,支持3.5/2.5寸两种规格。相较于DXP系列的卡扣而言,便捷性稍弱。在安装硬盘过程中,只需将硬盘推入,螺丝孔位即可对其,没啥门槛。

将硬盘安装好,接入电源与网络,即可开始部署!
激活&部署
强烈建议用路由器组个内网,无论是学生党还是一般用户,想要有比较良好的体验,不折腾上手即用,所以说最好是将NAS部署在内网中。
当NAS上的网络指示灯由红转白时,即可使用手机或电脑端APP识别设备,随即即可绑定手机号并注册管理员账号,就和一般APP注册账号差不多。

DH4300 Plus毕竟是偏向于面对家用场景定位,可通过手机靠近NAS前的NFC感应区,即可辅助下载APP和连接,这点好评。


注册完账号进入引导界面,即可部署硬盘,选择RAID类型。
四盘位能组更多阵列类型,即可以组容量无损的Basic/JBOD/RAID 0,追求最大容量,装一些影视剧,音乐等常规资源,做好种子备份即可。
也可以组RAID 1/RAID 5/RAID 10,牺牲一部分存储空间用作备份校验,当部分硬盘损坏时,还有恢复的机会。更推荐用于备份重要文件场景。

本人最终选择组建RAID 0和Basic这两种容量最大化形式。
首先,本人80%的需求在于观影和资源转存,其数据有很大可替代性。其次,重要资料除了同步上传NAS外,还会在两台电脑和移动硬盘上备份。
毕竟,异地多端备份,才是保障数据安全之王道。

除了部署硬盘并组建阵列外,UGOS自带的UGREENink是一定要开启的,这可是作为易用性NAS的王牌功能之一,你也不想整了NAS后发现外网访问困难,还得折腾中继服务器吧?

部署完毕后,咱们就要聊聊DH4300 Plus的系统——UGOSPro了,经过半年的更新,其进步可不小。同时也回答一个疑问——NAS能用来干啥?
UGOS Pro日常体验
图形化和应用化,是实现NAS操作系统易用性的关键之一,类似手机操作逻辑的UGOS主界面,结合较为细致的引导,初次上手没啥阻碍,跟着引导走就是。
先来聊聊比较核心的功能——影视中心、相册、同步备份和文件管理等部分。

影视中心
通过本人这半年多对于DXP2800的体验,我几乎花费了60%的时间在影片下载和观影上,绿联UGOS在方面一条龙功能做得挺好,操作逻辑和常规APP没有区别。
一般影视资源的获取可通过内置迅雷下载、网盘工具、下载器以及Docker项目——qBittorrent(类似的有比特彗星)实现,基本能涵盖大部分的资源获取途径。

由于我将DXP2800的影视职能转移到DH4300 Plus中,需要转移数据库和重建影视中心。
虽然目前暂时不支持硬盘直接转移,但可通过内网SMB分享外部文件夹,再将数据转移到新设备中,还算方便。然后将影视文件夹分类,添加到媒体库等待识别即可。

得益于TMDB+智能识别双重刮削,当影视命名较为明确的情况下,识别率较高,尤其是热门影片。相较于老牌NAS产品还需要额外通过jellyfin等Docker项目才能实现的功能,UGOS Pro集成在应用中的形式还是很方便。



除了在媒体库中浏览影片,还可通过智能分类选择,或者干脆自建合集,我选择将纪录片统一塞进一个合集当中,便于浏览。
当部分影片较为古老,或者命名复杂导致识别异常,也可通过手动识别纠正。
总得来说,在界面观感,识别并分类以及自定义方面,UGOS中的影视中心在高频更新后变得更易用,也没啥乱七八糟调整,设置很符合直觉。

足够的CPU性能与VPU(视频处理单元),使DH4300 Plus在播放器性能方面应对4K蓝光原片没问题,CPU占用仅在10%,VPU占用则在80%,看来的确是在干活。
影视中心前段时间新增了在线字幕检索与导入功能,解决了蓝光片源无内嵌字幕的问题。同时码率切换的解码过程也控制在5s内,有所进步。

蓝光影片更推荐在内网观看,以60GB容量的《肖申克的救赎》为例,大幅拖动进度条需要300Mbps的带宽能做到“即拖即放”,正常播放也得保证稳定在60Mbps的带宽才行。
在本人校园网环境下,下行带宽接近200Mbps,而上行只能在40—60Mbps摆动,完全无法满足快进需求,甚至正常播放都有些困难。


故个人更推荐在外网环境下,牺牲一部分码率以保障流畅度。以目前UGREENink目前的转发效率,能轻松做到1080P画面下爽快拖动进度条,稳定播放仅需要20Mbps的上行带宽即可。

电视剧/纪录片观看支持剧集自动分类以及新增跳过片头片尾功能,利好“一剧追到底”的用户,解放双手。
同时,如果你有支持HDR的显示器,也可以在设置中开启HDR功能,体验更加明确的光影变换,一般高码率的视频源都是支持这一格式的。

以雷鸟U8通过DXP2800的SMB功能播放流浪地球为例,开启HDR以后,影片的色彩会更加饱满,且光源的表达会更准确。

作为学生党,个人认为NAS是能很好满足影视资源收集的癖好的。相较于网盘资源的易丢失,以及常规硬盘盒不便浏览的困难,NAS是一个很好的解决方案。
DH4300 Plus作为易用性NAS,只要能在宿舍搞定内网,整个破解路由器并且按要求部署好,其它包括内网穿透,S****等功能都被集成在UGOS当中,并且内外/外网观影与资源管理也十分方便。
相册
除了娱乐与满足囤囤鼠癖好外,相册算是我用的比较多的APP,相较于电脑上枯燥的文件夹,UGOS上的相册反倒更加人性化。
APP端支持媒体/实验照片自动备份。本人一般隔一段时间打开手机APP端,看看视频电影啥的,顺便后台完成备份,没必要刻意专门挂起APP进行操作。

地理位置归纳,利好科研党跑野外,或者看看自己的工作/旅游足迹也是很方便的。有的时候看看照片在地图上的位置戳,再浏览一遍照片,挺有时空感的,这一移植功能挺不错。

DH4300 Plus上的AI功能相较于去年DXP2800上的更加强大。
除了工具箱中如下基本功能与自定义训练外,DH4300 Plus通过处理器中的NPU模块,提高AI识别效率。这样除了专门通过的自定义AI学习识别小众物体——例如培养基外,还能够直接检索常见物品。

以键盘为例,大部分主体较为符合的照片都能被筛选出来。虽然不够准确,会有遗漏或者乱入,但它识别快呀!大约3s左右即可出结果。
用它来给科普文章提供基本素材还是很方便的,毕竟只需要插入一张键盘/鼠标/耳机的图片即可。

相较于“识物”,个人更倾向于“识字”功能,它的准确率是相当高的,外出开会论坛的工作照都能够快速筛选出来,例如最近的动物生态学方向讲座,屏幕上的标题即可参与筛选。
更进一步,例如手机中保留了大量的文档照片,也可用此功能进行快速筛选,而不是在相册中逐个翻找。

这些额外的功能需要在设置中开启,进行初步识别,以便于后续的关键词检索识别。目前支持人物、文字、宠物、敏感内容识别和描述识别。
相较于最初需要导入图片的AI模型训练,这类智能模型会更易用,也能满足一般的检索需求。

除此之外,照片分享功能也挺实用。可以将照片生成链接分享出去,还不需要客户端即可观看或下载。并且可以对分享项目进行实时管理,及时终止分享。
个人热衷于将近期的实验照片和数据记录分享给同门,相较于微信分享更便捷,没有严格数量上限,并且也便于下载与保存。

音乐
音乐专辑识别没啥问题,识别率在90%以上,毕竟本人上传的高码率音频文件是被炮制过的,封面全部被替换掉了。
所有的格式,包括500MB容量以上的FLAC文件都可正常识别播放,利好音频囤囤鼠,用于快速试听绝对没问题,真要用前级,把文件夹通过SMB映射到电脑中即可,完全不用担心电脑硬盘容量告急。


文件备份/同步
UGOS的同步/备份功能支持电脑同步NAS,也支持NAS间相互同步。本人用的比较多的是将自媒体素材和实验素材进行备份,同名文件不覆盖,以便溯源。
同步方式也支持自动和手动两种模式,能覆盖大部分使用场景。

UGOS其它功能
绿联UGOS的更新频率不用说,新品季甚至能做到一周一更新,DXP2800如今也能半月一更,小组件、内置浏览器等新功能大多能一视同仁,同步更新。
这里便来聊聊更新N轮的UGOS Pro在操作逻辑和常用功能上体验如何。
Server Message Block服务
它支持PC和其它NAS在内网直接访问其具体文件夹中的文件,并对支持对其修改等操作,相当于从NAS中映射出来的硬盘一样,对文件享有绝对的管理权。
并且访问速度也取决于路由器的性能,本人千兆路由器可以稳定在100MB/S。用来转存下载好的电影,或者其它大型文件较为方便。

文件夹逻辑与管理
UGOS Pro中的文件管理可以说有两套不同的逻辑。
个人/共享这两类大文件夹需要设置其存储位置和访问权限,与其说是文件夹,反倒更像“个人硬盘分区”,这个文件夹需要在建立之初进行基本设置和归属处理,无法进行复制粘贴等操作。
并且删除也需要管理员账号和密码,文件夹权级很高,非管理用户几乎无权处理这些文件夹。

而在个人/共享文件夹之中的子文件夹或文件,则类似PC中的常规文件,可以复制转移到其它文件夹中去,也可以直接删除。
同时也支持热键操作和直接从PC拖拽文件,文件管理比较轻松,删除后的文件会被转移到回收站,这操作逻辑很像Windows啊!

当然,管理员用户也不是无敌的存在,其他访问NAS的用户对自己的个人文件夹享有绝对的访问权,管理员也无权打开被用户隐藏的个人文件夹。
可见NAS的文件管理系统,相当于一套别墅,个人用户可以在自己的房间和公共区域活动,房东管理协调整个别墅空间,未经用户同意,房东也不能私闯用户私人房间。

文档分享
互联网精神被NAS给实现了!无需密码,无需APP,无容量限制!只要上行带宽足够,我就能将“宇宙”分享出去。朋友想要游戏备份,或者是蓝光电影,又或是实验数据?选择文件,点击分享,生成链接,丢过去即可,用过都说方便。

甚至视频/图片/音频文件还支持在线预览,这下连下载都省了。

快照
6月新增的一个Btrfs文件保护功能,通过少量的储存占用,记录特定时间点的个人/共享文件数据,防止数据丢失。
这需要在创建存储空间时,将文件系统设置为Btrfs,而非默认的ext4。个人建议将备份盘设置为该格式,常规数据盘用ext4以保障性能。


Docker
在应用中心预设Docker项目简直是UGOS最伟大的发明,不用调试加速器配置,不用考虑兼容性,直接下载安装即可,利好小白用户。
目前支持的项目不多,有qBittorrent、Firefox浏览器、思源笔记啥的,期待后续多多更新。


如果你想在后续整点进阶玩法,例如虚拟机或者花活更多的Docker项目,个人更推荐上DXP系列,x86架构的处理器支持内存扩容至16GB,兼容性也会更好,还能更好的折腾虚拟机和软路由。

文件系统保护
这算是国产NAS的一个鲜明的特性,转移文件所在存储池、新建/删除存储池等涉及到数据管理的操作都需要输入账户密码,习惯后倒也还好。

绿联帮助中心
在11月接触DXP2800的时候,大部分的Docker容器的安装,以及虚拟机的安装都是通过绿联NAS帮助中心实现的。其教程多到看不完,初级的设置到高级进阶的项目都有详细的介绍。
光教程和应用指南,就有600余篇内容,遇到什么问题就先去帮助中心看看吧!


如果实在搞不定,还可以在绿联NAS私有云公众号转人工,半夜11点都在线,工程师头发要掉光了。

账号切换
本以为DH4300 Plus和DXP2800两台设备之间切换会比较麻烦,其实在主界面右上角点击个人中心即可切换账号。两台设备在线时,外网切换都是秒换系统,体验不错。

总结
绿联DH4300 Plus适合哪些人?
作为DH系列的开山之作,DH4300 Plus首发价1299元,现价1199元,如果后续上国补能做到1000元以内的好价。
相较于DXP系列更适合家庭与个人用户,不追求进阶功能,满足日常娱乐和备份需求即可。8GBLPDDR4X+8核心ARM处理器+NPU/VPU单元,视频和AI性能能满足高码率视频播放与照片管理需求。
它算是更接地气的产品——性能够用,盘位够多,价格够便宜。
DH系列和DXP系列该怎么选?
DXP系列适合发烧友和需要大带宽多并行操作的企业级用户,选择DXP4800急及以上版本,多盘位还支持双2.5G网口,配合高性能路由器,将NAS中的硬盘当本地硬盘使用都没问题。
DH系列则更为接地气,四盘位,支持NFC一碰即连,配合够用的性能,更加亲民的价格与功耗,个人用户和小型团队会更适合选择它。
更多游戏资讯请关注:电玩帮游戏资讯专区
电玩帮图文攻略 www.vgover.com













![[奇怪生物日志特刊]你认得表情包里,鼻子这么长的狗狗吗?](https://imgheybox1.max-c.com/bbs/2026/04/01/a005ad31a4039d77327ec8a1e84da7f9.jpeg?imageMogr2/auto-orient/ignore-error/1/format/jpg/thumbnail/398x679%3E)



